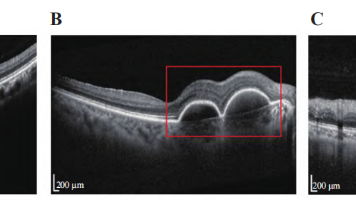

个人成就
TA的专栏
-
 9块9高质量计算机毕设论文 付费37篇
9块9高质量计算机毕设论文 付费37篇 -
 offer分享+面试经验 付费37篇
offer分享+面试经验 付费37篇 -
 机器学习案例分享 付费60篇
机器学习案例分享 付费60篇 -
 机器学习实战 付费37篇
机器学习实战 付费37篇 -
 深度学习机器学习实战 付费45篇
深度学习机器学习实战 付费45篇 -
 中文核心论文实战项目集合 付费18篇
中文核心论文实战项目集合 付费18篇 -
 计算机毕设 付费73篇
计算机毕设 付费73篇 -
 EI会议中文核心SCI 11篇
EI会议中文核心SCI 11篇 -
 python实战100例 48篇
python实战100例 48篇 -
 r语言数据分析机器学习 2篇
r语言数据分析机器学习 2篇 -
 数据库 1篇
数据库 1篇 -
 c语言实战 2篇
c语言实战 2篇 -
 机器学习实战100例 17篇
机器学习实战100例 17篇 -
 深度学习从入门到精通 18篇
深度学习从入门到精通 18篇 -
 自然语言处理从入门到精通 9篇
自然语言处理从入门到精通 9篇 -
 python从入门到精通学习之路 7篇
python从入门到精通学习之路 7篇 -
 python
python -
 matlab实战100例 1篇
matlab实战100例 1篇 -
 matlab 4篇
matlab 4篇 -
 计算机案例实战 4篇
计算机案例实战 4篇 -
 python杂记 18篇
python杂记 18篇
TA关注的专栏 1
TA关注的收藏夹 0
TA关注的社区 0
TA参与的活动 11
TA的推广
兴趣领域
设置
创作活动更多

AI 镜像开发实战征文活动
随着人工智能技术的飞速发展,AI 镜像开发逐渐成为技术领域的热点之一。Stable Diffusion 3.5 FP8 作为强大的文生图模型,为开发者提供了更高效的图像生成解决方案。为了推动 AI 镜像开发技术的交流与创新,我们特此发起本次征文活动,诚邀广大开发者分享在 Stable Diffusion 3.5 FP8 文生图方向的实战经验和创新应用 本次征文活动鼓励开发者围绕 Stable Diffusion 3.5 FP8 文生图方向,分享以下方面的内容: 1. 技术实践与优化 - Stable Diffusion 3.5 FP8 模型架构解析与优化技巧 - 文生图生成效果的提升方法与技巧 - 模型部署与加速策略,例如使用 Hugging Face、Diffusers 等工具 - 针对特定场景(例如二次元、写实风)的模型微调与定制化开发 2. 应用场景探索 - Stable Diffusion 3.5 FP8 在不同领域的应用案例分享,例如游戏设计、广告创意、艺术创作等 - 利用 Stable Diffusion 3.5 FP8 实现图像编辑、图像修复、图像增强等功能的探索 - 结合其他 AI 技术(例如 NLP、语音识别)构建更强大的应用 3. 创新应用与思考 - 基于 Stable Diffusion 3.5 FP8 的创新应用场景设计 - AI 镜像开发的未来发展方向的思考与展望 - 对 AI 镜像开发伦理、安全等问题的探讨
28人参与 去参加
- 最近
- 文章
- 专栏
- 代码仓
- 资源
- 收藏
- 关注/订阅/互动
更多


最近
文章
专栏
代码仓
资源
收藏
关注/订阅/互动
社区
帖子
问答
课程
视频



搜索 取消
联邦学习训练 lstm 详细代码实战